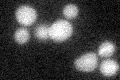
YPR054W
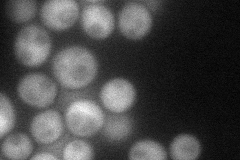
YPR054W
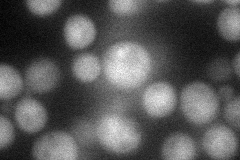
YPR054W
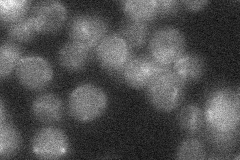
YPR054W
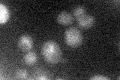
YPR054W

View description
Middle sporulation-specific mitogen-activated protein kinase (MAPK) required for production of the outer spore wall layers; negatively regulates activity of the glucan synthase subunit Gsc2p
Localization:
Intensity:
Fold change:
Significance:
-
C’ GFP library in SD
below threshold17.58 -
N' NOP1pr-GFP in SD
cytosol61.0445 -
N' TEF2pr-mCherry in SD
punctate40.3246 -
N' NATIVEpr-GFP in SD
below threshold16.2717 -
N' TEF2pr-VC and Cyto-VN in SD

#N/A0 -
C’ GFP library in SD+DTT

cytosol15.790.89No -
C’ GFP library in SD+H2O2

cytosol15.840.9No -
C’ GFP library in Starvation Media
cytosol24.711.4No -
C’ GFP library on the background of Pup2-DaMP

below threshold -
C’ GFP library on the background of CCT mutant

below threshold16.63310.945699No
